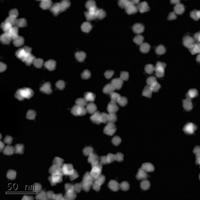
Positions visual

Positions
We are seeking excellent candidates for Postdoctoral Research Associate (PDRA) and DPhil (PhD) positions. We are an academically focused, yet friendly and supportive group and we always aim to enjoy our science. Do join us!
For a full list of current PDRA opportunities, please review the listings below and at jobs.ox.ac.uk.
For the latest DPhil projects, see the overview below and the Department of Materials project catalogue on the Materials DPhil projects page.
If you are interested in any of these projects or in proposing your own, please get in touch with us, briefly outlining your background, research interests, and relevant experience.
DPhil Projects
9

Distinguishing Bulk and Surface Redox Processes in Li-ion Battery Cathodes
Rechargeable Battery InterfacesProf R. J. Nicholls, Prof Robert Weatherup

Phase Transitions in 2D Materials and Thin Films Using Machine Learning
Electronic Structure SimulationsDr Zac Goodwin, Prof Rebecca Nicholls, Prof Robert Weatherup

Understanding the Electrical Double Layer of Localized High Concentration Electrolytes
Electrolyte Solvation and TransportDr Zac Goodwin, Prof Robert Weatherup

Mapping the Structure and Chemical State of Nanoparticle Catalysts for Sustainable Reactions
ElectrocatalysisProf Robert Weatherup, Christopher Allen



